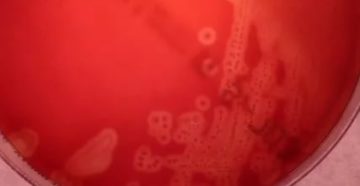
Streptococcus agalactiae у мужчин

Альвеолярный эпителий и аэрогематический барьер На рисунке изображен сегмент альвеолярной перегородки (АП) под большим увеличением…
Рубрика “Разное”
Категория: Разное
Симптомы и лечение липомы головного мозга Головной мозг, как и иные внутренние органы, подвержен заболеваниям,…
Синекод и пульмикорт Чтобы лечение оказало наиболее эффективный результат, врачи прописывают комбинации препаратов с разным…
Стоптуссин или Лазолван: что лучше и можно ли одновременно, сравнение Препарат – популярный аналог Эреспала….
Что такое инфильтрация лёгочной ткани: признаки и симптомы инфильтрата в лёгких Изначально специалист должен определить,…
Почему нельзя гулять на улице с ребенком после прививки и на какой день можно Молодые…
Инфильтрат в легких: что это такое, симптомы и лечения заболевания Порой в области ткани может…
Терафлю и алкоголь Совместимость Терафлю и алкоголя может вызвать некроз гепатоцитов печени, поражение клеток головного…
Уход за пирсингом септума ЭТО БОЛЬНО? При правильной технике выполнения этот пирсинг является одним из…
Стрептококк у мужчин — инфекция мочеполовой системы в уретре Род стрептококков насчитается более 100 различных…